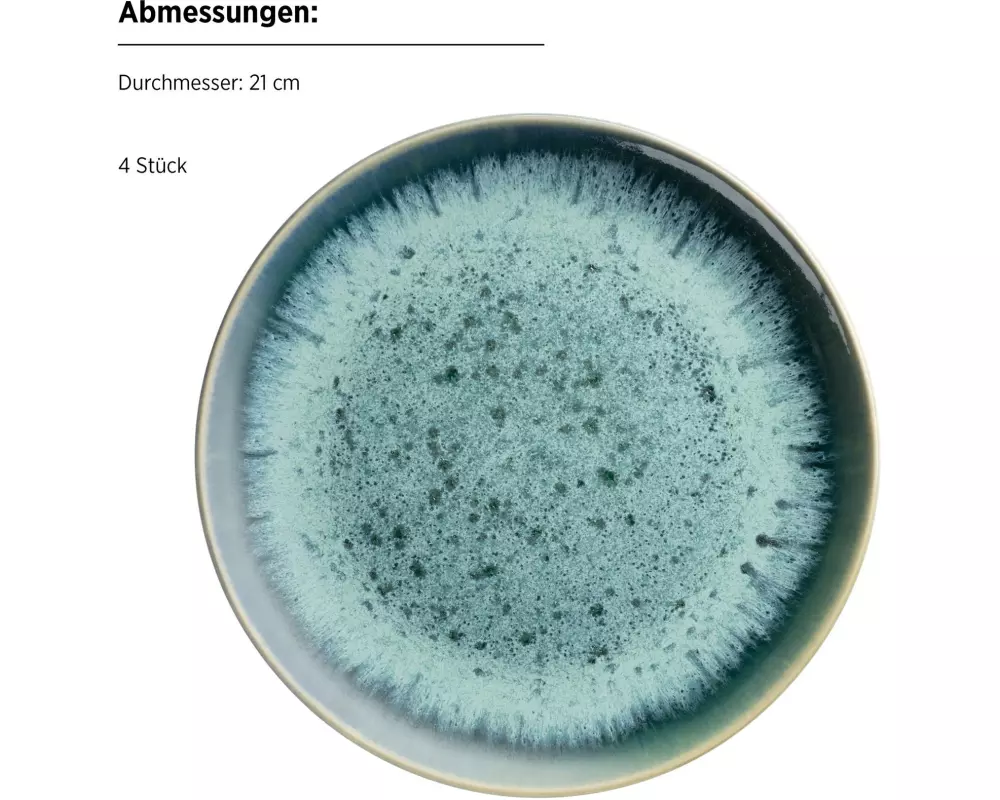
image

Auf Lager:
3
Teller
Mäser Frühstücks- & Dessertteller Carellia 12-teilig, Blau
12-teiliges Frühstücksset
Produkt bewerten
Material: Keramik
Teller Typ: Frühstücks- & Dessertteller
Detailfarbe: Blau
Verpackungseinheit: 1 Stück
Form: Rund
2 Jahre
Garantie
Hersteller:
Mäser Hersteller-Artikel-Nr.: 935513
Unsere-Artikel-Nr.: A3RP3V2KC
EAN: 9010933028331
Auf Lager:
3
Zustellung: Di, 09.06.2026
Versand: Kostenlos
-21.9 %
CHF 269.–
CHF 210.–
Beschreibung
Set bestehend aus 4 Dessert.- bzw. Frühstücksteller, 4 Schüsseln, 4 Kaffeebecher. Grösse der Teller: 23 cm, Schüsselchen: 15 cm. Fassungsvermögen Kaffeebecher: 430 ml. Geschirr-Set für das Frühstück oder Dessert bei einem Gedeck für 4 Personen. Aus hochwertigem Keramik (Steinzeug) produziert. Für die Spülmaschine geeignet.
Spezifikationen
Farbe
- Blau
Form
- Rund
Material
- Keramik
Mikrowellenfest
- Ja
Set
- Ja
Spülmaschinenfest
- Ja
Teller Typ
- Frühstücks- & Dessertteller